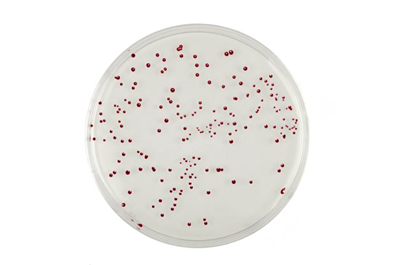

Brilliance CampyCount Agar gotowa pożywka do oznaczanie Campylobacter
Gotowe podłoże do oznaczenia bakterii Campylobacter
Opakowanie - 10 szt.
Płytki - 90 mm
Opis
Pożywka chromogenna
Alternatywną metodą oznaczania liczby Campylobacter jest zastosowanie pożywki chromogennej np. Brilliance CampyCount. Jest to wysoko selektywna pożywka mająca w składzie kombinację soli (zastępujących węgiel lub krew stosowaną w tradycyjnych pożywkach), czynników wzrostowych, aminokwasów i buforów, dedykowana do oznaczania liczby C. jejuni i C. coli w drobiu. Płytki przed użyciem powinny być dokładnie wysuszone. Wyrosłe kolonie są ciemnoczerwone. Ze względu na prostotę wykonania i łatwość interpretacji wyniku metoda ta jest przyjazna dla użytkowników z małym doświadczeniem w badaniu Campylobacter.
Pożywka chromogenna Brillance CampyCount
Odróżnienie od innych bakterii Gram(-)
Potwierdzenia dokonuje się testem O.B.I.S. Campy. Służy on do odróżnienia Campylobacter spp. od innych Gram(-) mikroorganizmów. Jest to test szybki (wynik otrzymujemy już po kilku minutach), łatwy do wykonania bez dodatkowego wyposażenia oraz bardzo prosty w interpretacji – za sprawą wyraźnej zmiany kolorów. Test wykrywa aktywność L-alanino aminopeptydazy (L-ALA) – enzymu, którego Campylobacteriaceae nie posiadają. Zmiana koloru wyklucza Campylobacter.
Bakterie z rodzaju Campylobacter od wielu lat są najczęstszą przyczyną zoonoz występujących w Europie. W Polsce kampylobakterioza jest chorobą rzadko diagnozowaną i rejestrowaną. Campylobacter spp. są szeroko rozpowszechnione w środowisku. Ich głównym rezerwuarem jest przewód pokarmowy ptaków i ssaków, w tym zwierząt hodowlanych. Drogi szerzenia się zakażenia u ludzi mogą mieć charakter bezpośredni, jak np. kontakt ze zwierzętami domowymi, hodowlanymi lub chorymi ludźmi oraz charakter pośredni (najczęściej) poprzez surowe lub niedogotowane mięso, zanieczyszczone mleko lub wodę. Duże znaczenie mają również zanieczyszczenia krzyżowe, występujące szczególnie w gospodarstwach domowych przy obróbce surowego mięsa drobiowego lub w środowisku szpitalnym na skutek nieodpowiedniej higieny rąk personelu. Jedną z przyczyn wysokiej zachorowalności na kampylobakteriozę jest niska dawka infekcyjna. Zachorowania występują sporadycznie. Epidemie pojawiają się rzadko i przeważnie związane są z mlekiem surowym lub wodą. Choroba ma postać zapalenia żołądkowo-jelitowego lub jelitowego. W jej przebiegu występują bóle brzucha, gorączka, biegunka i nudności. W rzadkich przypadkach w jej następstwie pojawiają się powikłania pozajelitowe: reumatologiczne lub neurologiczne. W Polsce w 2017 roku zarejestrowano 885 przypadków zachorowań na kampylobakreriozę.
W powyższym linku znajdą Państwo bazę aktualnych certyfikatów firmy OXOID. Wystarczy wpisać numer LOT zamówionej przez Państwa partii, w celu uzyskania odpowiedniego certyfikatu.
Koszty dostawy
Cena netto, nie zawiera podatku
darmowa i wygodna wysyłka
już od 800 zł netto
Najwyższa jakość
produktów potwierdzona certyfikatami
Zakupy 24h na dobę
wygodne i bezpieczne
bezpłatna konsultacja
z ekspertem online